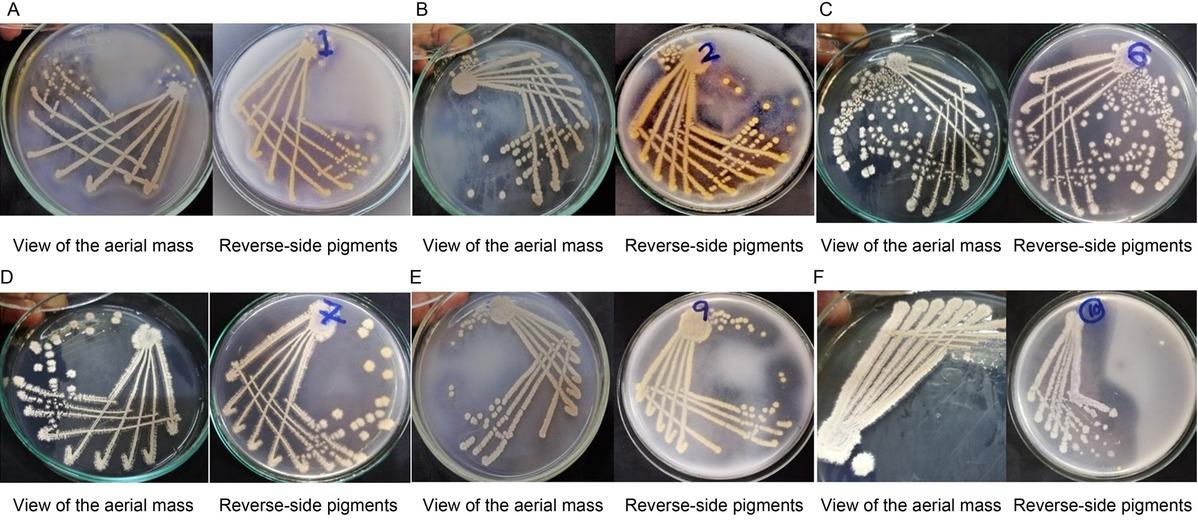
Colony morphologies of actinomycete isolates. The view of the aerial mass and reverse-side pigment colors of isolates Ac-1 (A), Ac-2 (B), Ac-6 (C), Ac-7 (D), Ac-9 (E), and Ac-10 (F) on modified-starch casein agar after 1–2 weeks of incubation at 28°C.

Fig. 1
Fig. 2

Fig. 3

Fig. 4

Fig. 5

Fig. 6

Fig. 7

Fig. 8

Antibacterial activity of actinomycete isolates against the test strains in the cross-streak assay_
| Strain ID | Test strain | |||
|---|---|---|---|---|
| Staphylococcus aureus | Escherichia coli | Bacillus cereus | Listeria monocytogenes | |
| Ac-1 | ++ | ++ | + | – |
| Ac-2 | ++ | + | + | – |
| Ac-6 | – | – | – | – |
| Ac-7 | – | – | – | – |
| Ac-9 | + | + | + | – |
| Ac-10 | – | – | – | – |
Comparison of growth of actinomycete isolates Ac-1 and Ac-2 under shaking and non-shaking conditions_
| Growth condition | Dry weight of the biomass (g)# | |
|---|---|---|
| Ac-1 | Ac-2 | |
| With shaking (at 100 rpm) | 0.023 ± 0.003** | 0.043 ± 0.006* |
| Without shaking | 0.000** | 0.057 ± 0.006* |
Characteristics of actinomycete isolates_
| Isolate name | Colony morphology | Gram’s reaction | Spore chain morphology | Catalase production | |
|---|---|---|---|---|---|
| Aerial mass color | Reverse side pigment color | ||||
| Ac-1 | greyish white | yellowish green | + | open spirals | + |
| Ac-2 | greyish white | yellowish orange | + | biverticillate with spirals | + |
| Ac-6 | white | – | + | flexuous | + |
| Ac-7 | white | – | + | flexuous | + |
| Ac-9 | greyish white | yellowish grey | + | open spirals | + |
| Ac-10 | white | – | + | pleomorphic bacilli | + |
Antibacterial activity of actinomycete crude pigment extracts against test strains in well-diffusion assay_
| Test organism | Average diameter of the zone of inhibition (mm) ± SEM* | |
|---|---|---|
| Ac-1 | Ac-2 | |
| Escherichia coli | – | 21.0 ± 0.5774 |
| Pseudomonas aeruginosa | – | 18.0 ± 0.0 |
| Staphylococcus aureus | – | 22.5 ± 0.2881 |